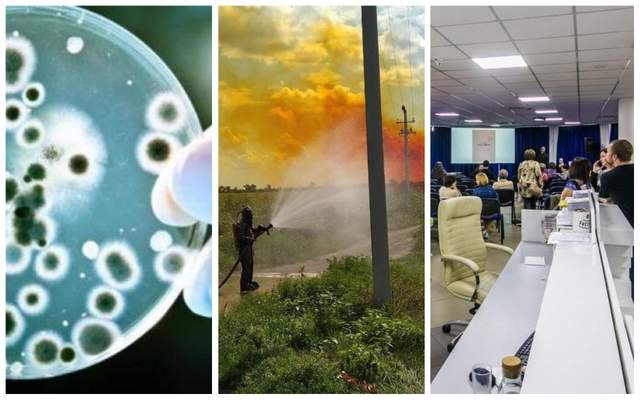

Стан Олега Сенцова погіршився
Адвокат українського режисера Олега Сенцова Дмитро Дінзе повідомив про погіршення стану політв'язня.
Він зазначив, що у Сенцова впав гемоглобін та почалися проблеми із серцем.
За словами Дінзе, Сенцов перебуває у поганому стані. Зокрема, у нього сильно знизився гемоглобін, що призвело до анемії, а також – дуже низький пульс, близько 40 ударів на хвилину.
Йому також стало зле через те, що в Лабитнангі стало дуже тепло, а в нього нині погана переносимість спеки,
– додав адвокат.
Дивіться відео коментаря адвоката Олега Сенцова про стан режисера:
За що в Росії засудили Олега Сенцова?Українського режисера затримали на території окупованого Криму 11 травня 2014 року. Його звинуватили в підготовці теракту у Криму під час незаконної анексії півострова Росією. Пізніше режисера звинуватили у зберіганні зброї та вибухівки.
У серпні 2015 року російський суд засудив Сенцова до 20 років ув'язнення в колонії суворого режиму в місті Лабитнангі. З 16 травня 2018 року Олег Сенцов голодує з вимогою звільнити усіх українських політв’язнів, утримуваних у Росії та в окупованому Криму.
Лістеріоз в Україні – зафіксовано летальний випадок
В Україні зафіксовано перший летальний випадок захворювання на небезпечну інфекцію – лістеріоз.
Як повідомили у прес-центрі Центру громадського здоров'я МОЗ України, станом на серпень 2018 року в Україні зафіксовано 2 випадки захворювання на лістеріоз.
Перший був виявлений на Львівщині – захворіла дівчина 1999 року народження на ангінозно-септичну форму лістеріозу. Після вчасного лікування вона одужала.
Другий випадок, на жаль, виявився летальним.
У Києві чоловік 1949 року народження помер від лістеріозу з ураженням тканини головного мозку. Сталось це ще у липні.
У відомстві додали, що кількість хворих може збільшитися, оскільки інкубаційний період недуги захворювання становить 70 днів.
В Україну бактерія могла потрапити в замороженій кукурудзі з Угорщини. Зараз її активно вилучають з продажу.
Витік азотної кислоти на Дніпропетровщині
Вдень 7 серпня на трасі Дніпро – Кобеляки – Решетилівка під Дніпром з автоцистерни витекла азотна кислота, випари якої здійнялися у повітря у вигляді помаранчевої хмари.
За інформацією надзвичайників, які прибули на місце аварії витекло приблизно 4 тонни азотної кислоти.
Рятувальники зробили водну завісу для того, щоб осіли випари, витік кислоти їм вдалось зупинити.
Постраждалих внаслідок надзвичайної події немає.
Дивіться відео з місця витоку азотної кислоти на Дніпропетровщині:
Масове затримання журналістів у Білорусі
У Білорусі затримали уже 8 журналістів опозиційних видань TUT.BY і "БелаПАН".
Відомо про затримання головного редактора інтернет-ресурсу TUT.BY Марини Золотової, затримано також редактора новин Ганну Калтигіну та журналістку агентства "БелаПАН" Тетяну Коровєнкову.
Серед затриманих також журналісти Уляна Бобоєд, Галина Власік, Дмитро Бобрик та Анна Єрмаченок. Усі вони є співробітниками редакції TUT.BY.
У Слідчому комітеті країни пояснили, що приводом для порушення кримінальної справи стало "повідомлення державного інформагентства "БелТА" про збої під час здійснення доступів до платної підписки послуг, які надавалися підприємством одному з його замовників".
У Білорусі затримали журналістів опозиційних видань
"Слава Україні" стане офіційним військовим вітанням
Президент України Петро Порошенко доручив розробити законопроект, який замінить військове вітання в ЗСУ радянського зразка "Здрастуйте, товариші!" та "Бажаємо (бажаю) здоров’я!" на "Слава Україні!" та "Героям слава!"
"Слава Україні" стане офіційним військовим вітанням
Адвокат українського режисера Олега Сенцова Дмитро Дінзе повідомив про погіршення стану політв'язня.
Він зазначив, що у Сенцова впав гемоглобін та почалися проблеми із серцем.
За словами Дінзе, Сенцов перебуває у поганому стані. Зокрема, у нього сильно знизився гемоглобін, що призвело до анемії, а також – дуже низький пульс, близько 40 ударів на хвилину.
Йому також стало зле через те, що в Лабитнангі стало дуже тепло, а в нього нині погана переносимість спеки,– додав адвокат.
Дивіться відео коментаря адвоката Олега Сенцова про стан режисера:
За що в Росії засудили Олега Сенцова?Українського режисера затримали на території окупованого Криму 11 травня 2014 року. Його звинуватили в підготовці теракту у Криму під час незаконної анексії півострова Росією. Пізніше режисера звинуватили у зберіганні зброї та вибухівки.У серпні 2015 року російський суд засудив Сенцова до 20 років ув'язнення в колонії суворого режиму в місті Лабитнангі. З 16 травня 2018 року Олег Сенцов голодує з вимогою звільнити усіх українських політв’язнів, утримуваних у Росії та в окупованому Криму.
Лістеріоз в Україні – зафіксовано летальний випадокВ Україні зафіксовано перший летальний випадок захворювання на небезпечну інфекцію – лістеріоз.
Як повідомили у прес-центрі Центру громадського здоров'я МОЗ України, станом на серпень 2018 року в Україні зафіксовано 2 випадки захворювання на лістеріоз.
Перший був виявлений на Львівщині – захворіла дівчина 1999 року народження на ангінозно-септичну форму лістеріозу. Після вчасного лікування вона одужала.
Другий випадок, на жаль, виявився летальним.
У Києві чоловік 1949 року народження помер від лістеріозу з ураженням тканини головного мозку. Сталось це ще у липні.
У відомстві додали, що кількість хворих може збільшитися, оскільки інкубаційний період недуги захворювання становить 70 днів.
В Україну бактерія могла потрапити в замороженій кукурудзі з Угорщини. Зараз її активно вилучають з продажу.
Витік азотної кислоти на ДніпропетровщиніВдень 7 серпня на трасі Дніпро – Кобеляки – Решетилівка під Дніпром з автоцистерни витекла азотна кислота, випари якої здійнялися у повітря у вигляді помаранчевої хмари.
За інформацією надзвичайників, які прибули на місце аварії витекло приблизно 4 тонни азотної кислоти.
Рятувальники зробили водну завісу для того, щоб осіли випари, витік кислоти їм вдалось зупинити.
Постраждалих внаслідок надзвичайної події немає.
Дивіться відео з місця витоку азотної кислоти на Дніпропетровщині:
Масове затримання журналістів у БілорусіУ Білорусі затримали уже 8 журналістів опозиційних видань TUT.BY і "БелаПАН".
Відомо про затримання головного редактора інтернет-ресурсу TUT.BY Марини Золотової, затримано також редактора новин Ганну Калтигіну та журналістку агентства "БелаПАН" Тетяну Коровєнкову.
Серед затриманих також журналісти Уляна Бобоєд, Галина Власік, Дмитро Бобрик та Анна Єрмаченок. Усі вони є співробітниками редакції TUT.BY.
У Слідчому комітеті країни пояснили, що приводом для порушення кримінальної справи стало "повідомлення державного інформагентства "БелТА" про збої під час здійснення доступів до платної підписки послуг, які надавалися підприємством одному з його замовників".
У Білорусі затримали журналістів опозиційних видань
Президент України Петро Порошенко доручив розробити законопроект, який замінить військове вітання в ЗСУ радянського зразка "Здрастуйте, товариші!" та "Бажаємо (бажаю) здоров’я!" на "Слава Україні!" та "Героям слава!"
"Слава Україні" стане офіційним військовим вітанням